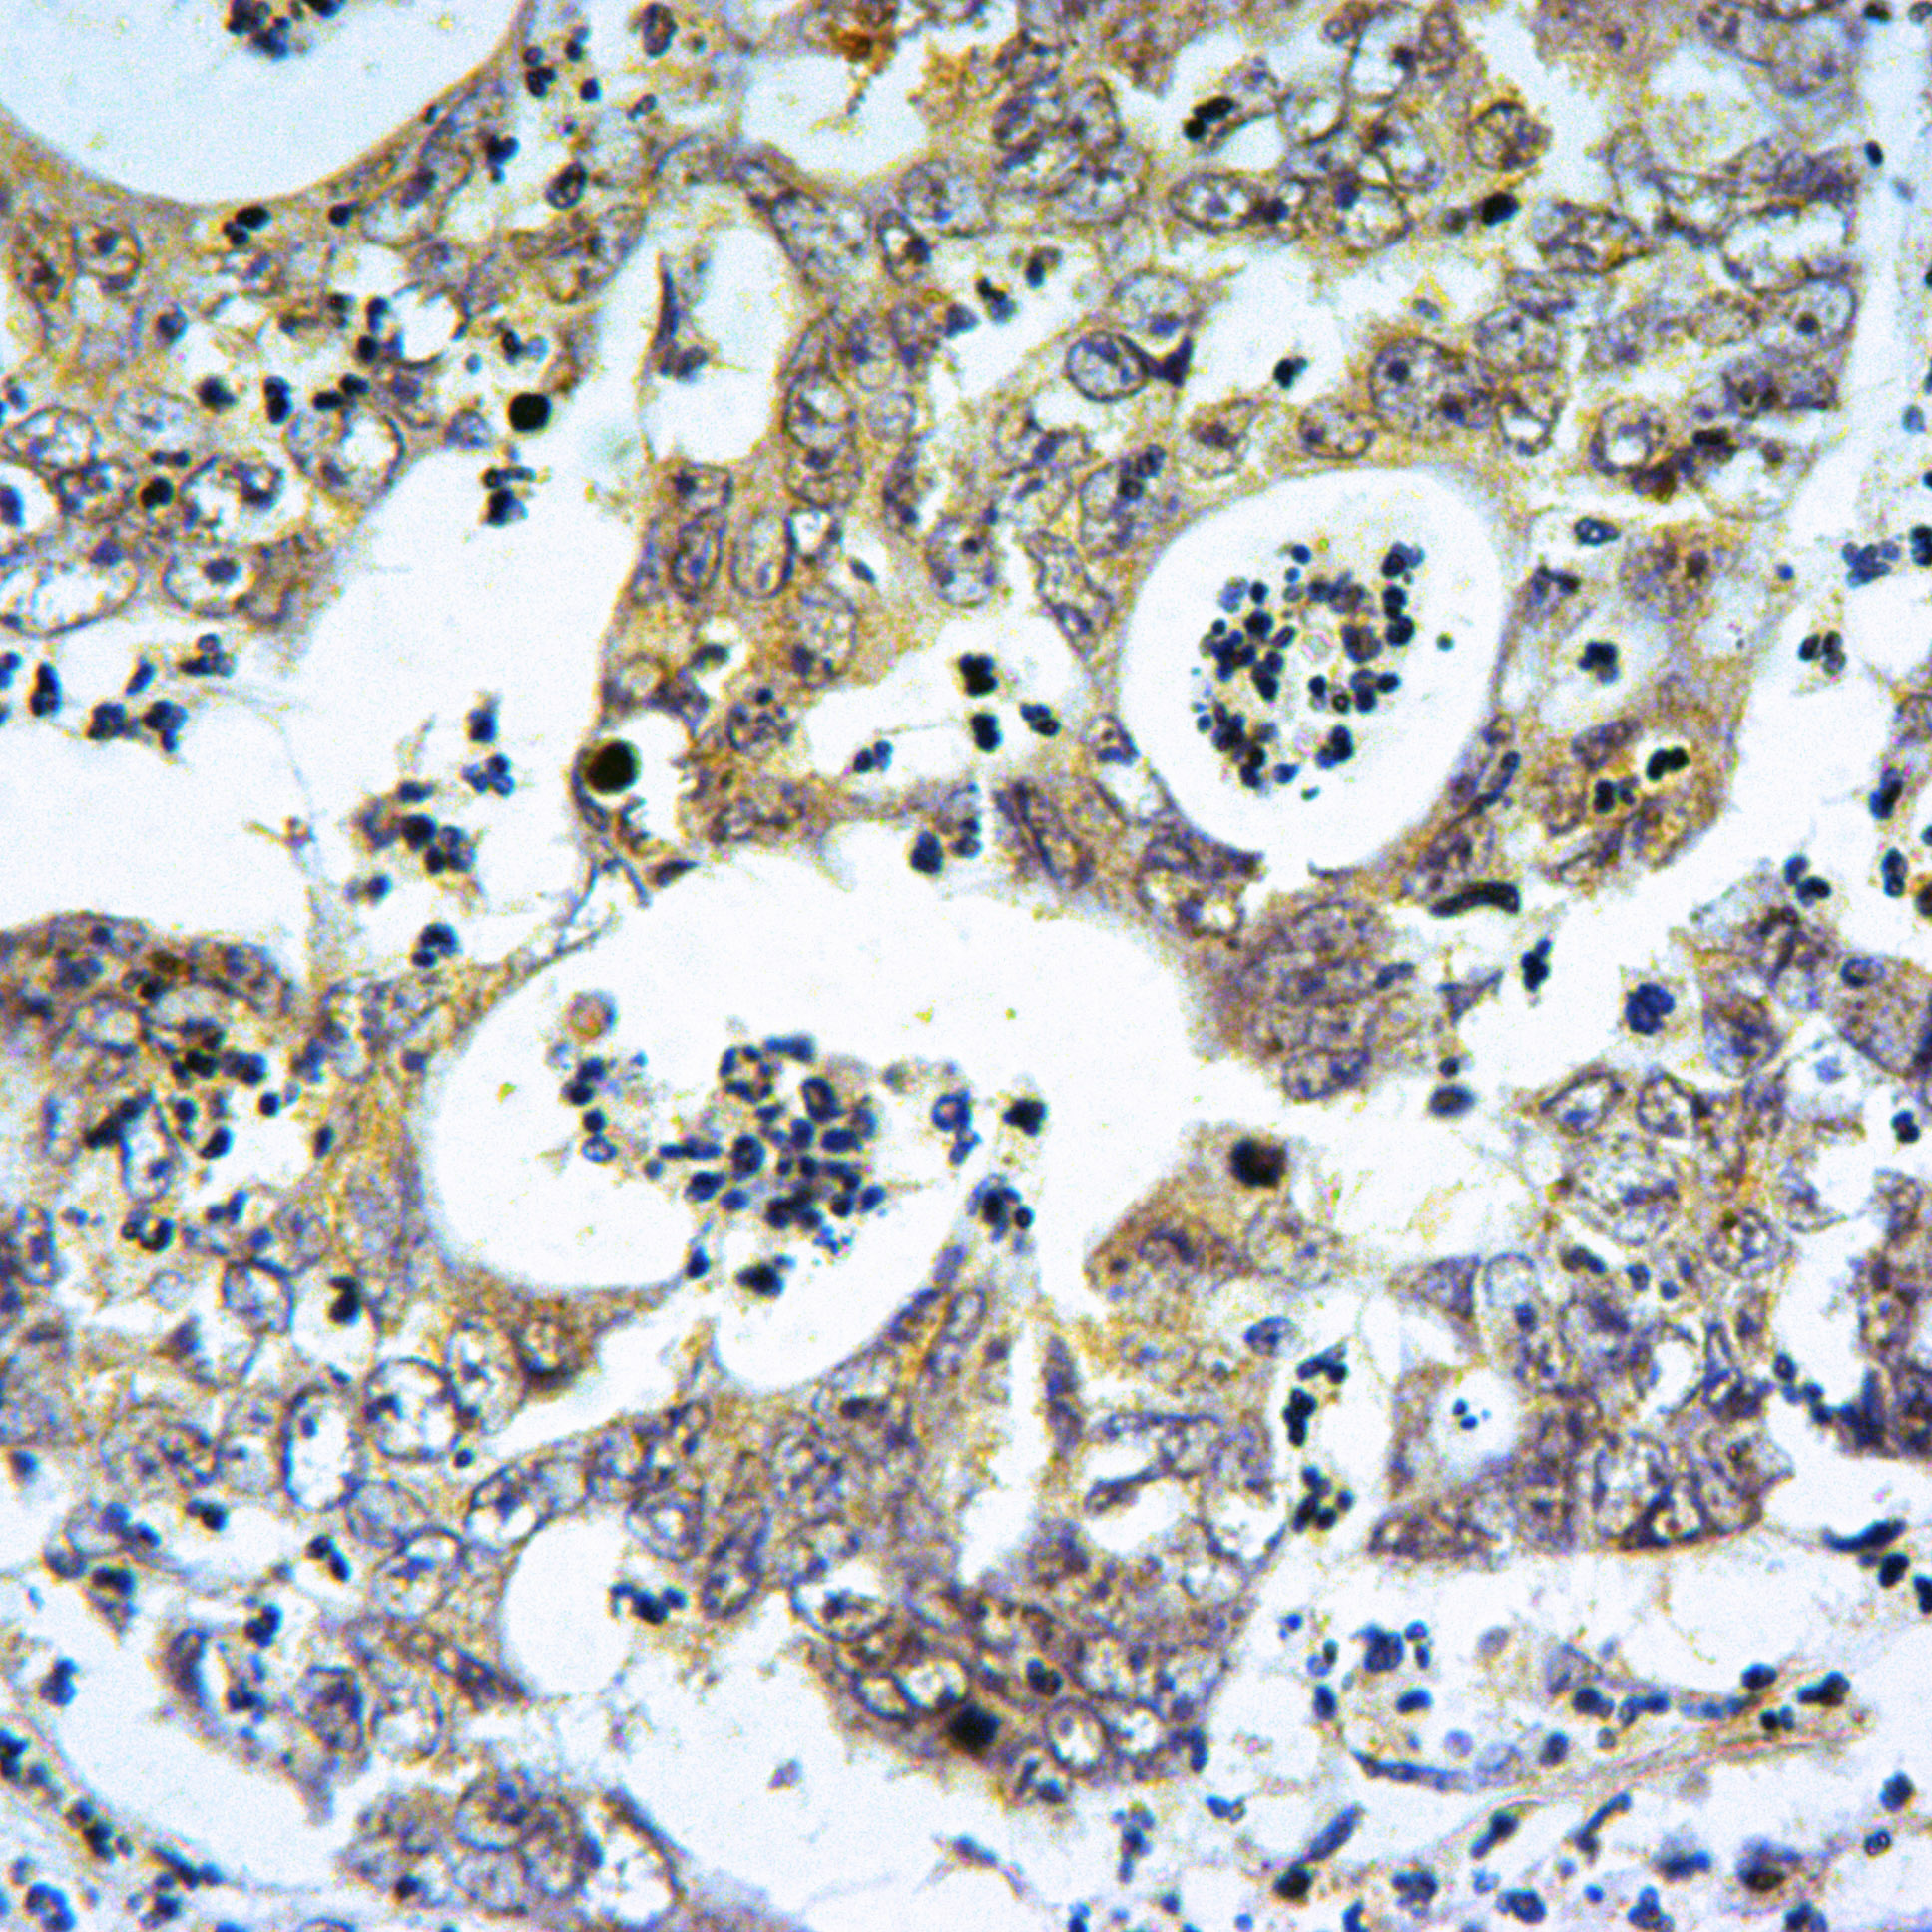
Rabbit polyclonal antibody to mT0R (Ser2481)

提醒成功

搜索
Rabbit polyclonal antibody to mT0R (Ser2481)
-
货号:
53023 -
别名:
Serine/threonine~protein kinase mTOR; FK506~binding protein 12~rapamycin complex~associated protein 1; FKBP12~rapamycin complex~associated protein; Mammalian target of rapamycin; mTOR; Mechanistic target of rapamycin; Rapamycin and FKBP12 target 1; Rapamycin target protein 1; MTOR; FRAP; FRAP1; FRAP2; RAFT1; RAPT1 -
应用:
WB IF IHC -
反应种属:
Human,Rat -
抗体类型:
Primary antibody -
Swissprot:
P42345 -
规格:
-
数量:
-+ -
说明书:
目录价¥1180

Rabbit polyclonal antibody to mT0R (Ser2481)
Description |
|---|
The mammalian target of rapamycin (mTOR, FRAP, RAFT) is a Ser/Thr protein kinase that functions as an ATP and amino acid sensor to balance nutrient availability and cell growth. When sufficient nutrients are available, mTOR responds to a phosphatidic acid~mediated signal to transmit a positive signal to p70 S6 kinase and participate in the inactivation of the eIF4E inhibitor, 4E~BP1. These events result in the translation of specific mRNA subpopulations. mTOR is phosphorylated at Ser2448 via the PI3 kinase/Akt signaling pathway and autophosphorylated at Ser2481. mTOR plays a key role in cell growth and homeostasis and may be abnormally regulated in tumors. For these reasons, mTOR is currently under investigation as a potential target for anti~cancer therapy. |
Specification |
|
|---|---|
| Aliases | Serine/threonine~protein kinase mTOR; FK506~binding protein 12~rapamycin complex~associated protein 1; FKBP12~rapamycin complex~associated protein; Mammalian target of rapamycin; mTOR; Mechanistic target of rapamycin; Rapamycin and FKBP12 target 1; Rapamycin target protein 1; MTOR; FRAP; FRAP1; FRAP2; RAFT1; RAPT1 |
| Swissprot | P42345 |
| clone | 5F9D10 |
| WB Predicted band size | ~289kDa |
| Host/Isotype | Rabbit IgG |
| Antibody Type | Primary antibody |
| Storage | Store at 4°C short term. Aliquot and store at ~20°C long term. Avoid freeze~thaw cycles. |
| Species Reactivity | Human,Rat |
| Immunogen | Synthetic peptide, corresponding to Human mT0R. |
| Formulation | 1mg/ml in PBS with 0.02% sodium azide, 50% glycerol, pH7.2 |
Application |
|
|---|---|
| WB | 1/500~1/1000 |
| IHC | 1/50~1/200 |
| IF/ICC | 1/50~1/200 |
Product Image
- Western blot (WB) analysis of mT0R (Ser2481) polyclonal antibody at 1:500 dilution Lane1:C6 whole cell lysate(40ug) Lane2:HEK293T whole cell lysate(40ug Lane3:MCF~7 whole cell lysate(40ug) Lane4:Hela whole cell lysate(40ug)
- Immunofluorescence analysis of MCF~7 cells using mT0R (Ser2481) antibody at dilution of 1:50.
- Immunohistochemistry of paraffin~embedded Human Colorectal cancer using mT0R (Ser2481) antibody at dilution of 1:50.
For Reseach Only
Application Key:WB - Western Blot | IHC - Immunohistochemistry | ICC - Immunocytochemistry | FCM - Flow Cytometry | ELISA - Enzyme-linked Immunosorbent Assay | IP - Immunoprecipitation
#53023

相关产品















 微信/QQ登录
微信/QQ登录


 首页
首页